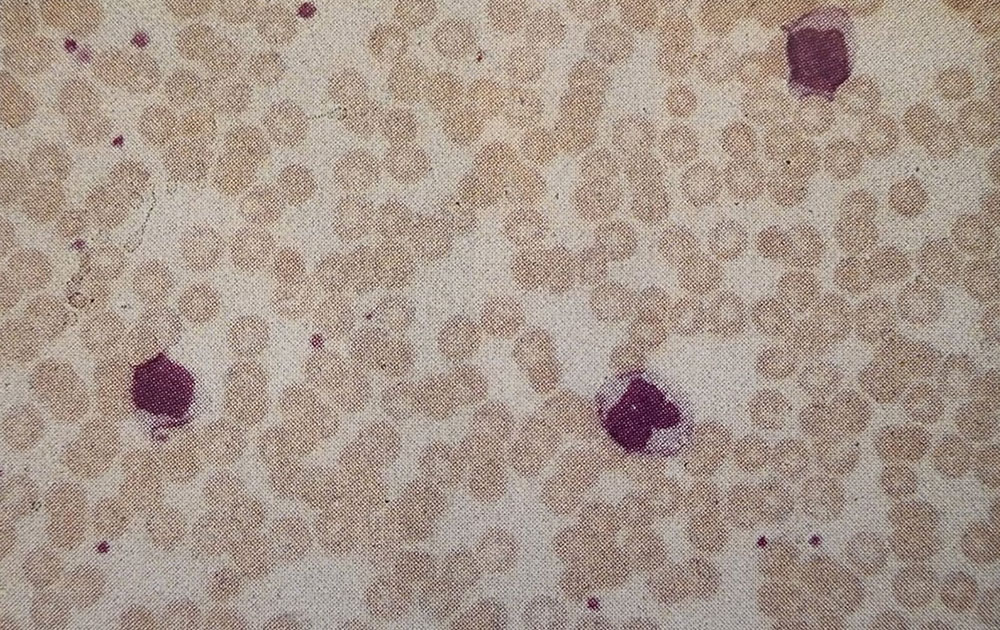

مطالعه موردی بیمار شماره 53، تشخیص شما چیست؟
شرح حال بیمار
یک مرد ۱۹ ساله که 3 روز گلودرد داشته است، به پزشک مراجعه کرد. در معاینه فیزیکی، شواهدی از فارنژیت حاد همراه با لنفادنوپاتی گردنی (بزرگی غدد لنفاوی) دوطرفه مشاهده شد. پزشک یک دوره درمانی با آمپیسیلین برای بیمار تجویز نمود که متعاقب آن، راش منتشر اریتماتوز (شکل 53a) بروز کرد. نتایج آزمایش شمارش کامل خون (Full Blood Count) بیمار به شرح زیر است:
- Hb: 12.3 g/dl
- WBC: 7.6 × 10⁹/L (لنفوسیتها 63٪، نوتروفیلها 34٪)
- Platelets: 150 × 10⁹/L

سؤالات
1. نظر شما درباره گسترش خون محیطی بیمار چیست؟ شکل (53b-53d) چیست؟
در اسمیر خون محیطی، لنفوسیتهای بزرگ و فعال (activated lymphocytes) مشاهده میشوند و شمارش خون محیطی وجود لنفوسیتوز نسبی را نشان میدهد. این یافتهها با تشخیص منونوکلئوز عفونی (Infectious mononucleosis) سازگار هستند. همچنین بروز راش پس از تجویز آمپیسیلین از تظاهرات شاخص محسوب میشود.
2. تشخیص چگونه تأیید میشود؟ اصول آزمایش مورد استفاده را توضیح دهید.
منونوکلئوز عفونی (glandular fever) در اثر عفونت با ویروس اپشتین–بار (Epstein–Barr virus; EBV) ایجاد میشود. این ویروس عمدتاً لنفوسیتهای B را آلوده میسازد، در حالی که لنفوسیتهای فعال مشاهدهشده در اسمیر خون محیطی در واقع لنفوسیتهای T واکنشی هستند. آزمایش غربالگری پاول–بونل (Paul–Bunnell test) یا Monospot به عنوان یک روش تشخیصی برای شناسایی آنتیبادیهای هتروفیل بهکار میرود. زیرا این آنتیبادیها مشخصه (اگرچه غیر اختصاصی ) عفونت EBV هستند. اصل آزمایش بر پایه عدم جذب این آنتیبادیها توسط سلولهای کلیه خوکچه هندی و جذب سریع آنها توسط گلبولهای قرمز گاوی است. اگرچه موارد مثبت کاذب نادر هستند، ولی میتوانند در برخی بیماریها از جمله لوپوس اریتماتوز سیستمیک مشاهده شوند. برای تأیید قطعیتر، شناسایی آنتیبادیهای اختصاصی علیه آنتیژنهای ویروس EBV به عنوان آزمون تشخیصی دقیقتر توصیه میشود.
3. تشخیص افتراقی چیست؟
عفونت با سیتومگالوویروس (CMV)، توکسوپلاسموز و آدنوویروس میتواند تصویری مشابه در خون ایجاد کند، اما در همه این موارد تست Monospot منفی خواهد بود.
4. چه عوارض مهمی ممکن است رخ دهد؟
لنفادنوپاتی منتشر و اسپلنومگالی از تظاهرات شایع منونوکلئوز عفونی به شمار میآیند و در موارد نادر، پارگی خودبهخودی طحال گزارش شده است. علاوه بر این، بروز عوارضی همچون ترومبوسیتوپنی، کمخونی همولیتیک خودایمن، و هپاتیت نیز ممکن است مشاهده شود.
توضیح تکمیلی
ویروس اپشتین–بار (EBV) در پاتوژنز نئوپلاسمهای نازوفارنکس نقش شناختهشدهای دارد و به عنوان یکی از عوامل همراه در بروز لنفوم بورکیت و سایر لنفومهای سلول B، بهویژه در بیماران دچار نقص ایمنی مانند گیرندگان پیوند یا مبتلایان به عفونت HIV، مطرح است. در بیماران HIV مثبت، لنفومهای مرتبط با EBV غالباً سیستم عصبی مرکزی (CNS) را درگیر میسازند (53e)






